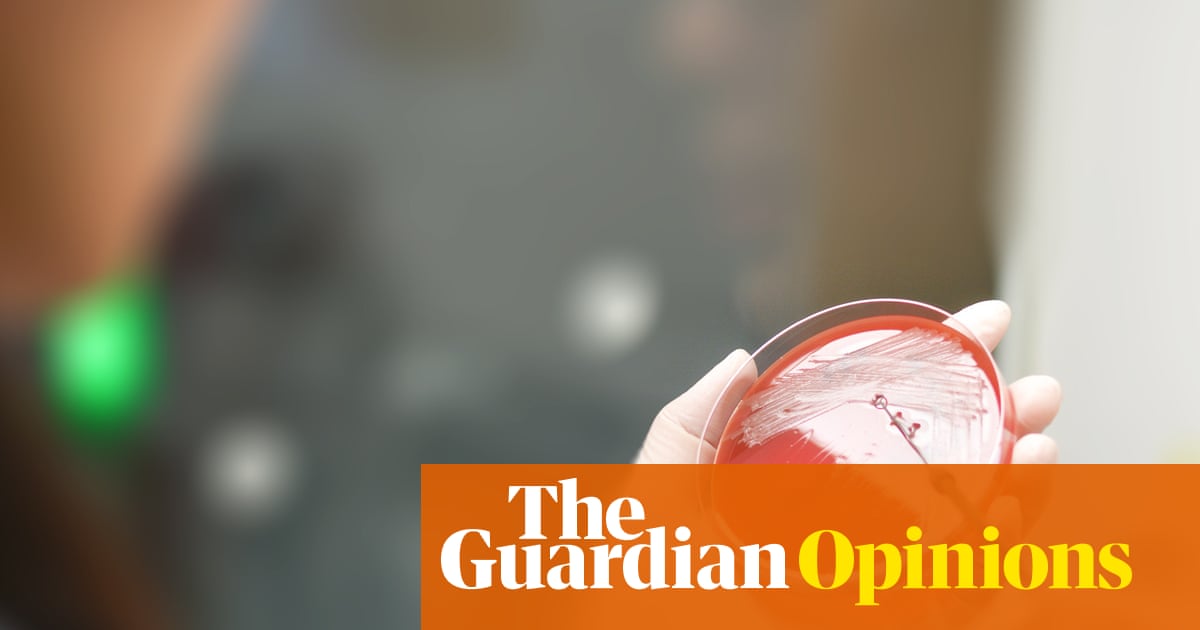

‘As new infections outpace new drugs, are we sleepwalking into a global health disaster?’
Much of the political momentum around the antimicrobial resistance crisis has dissipated, but a new report shows the danger to our health has not...
Redirecting to full article...